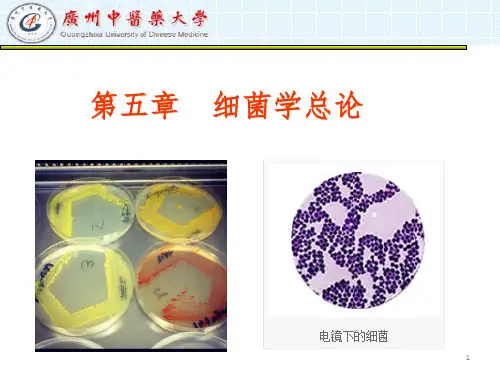

细菌学总论PPT课件
- 格式:ppt
- 大小:4.76 MB
- 文档页数:47


细菌学总论周亚滨微生物学教研室绪论(0.5学时)本章要点1. 微生物的概念;2. 微生物的种类;3. 微生物的发展简史;学习提纲微生物------一、存在于自然界中,形体微小,结构简单,肉眼看不见,必须借助光学显微镜或电子显微镜放大数百倍、数千倍,甚至数万倍才能观察到的微小生物。
二、微生物的种类微生物种类繁多,按其大小、结构、组成等,可分为三大类:真核细胞型微生物原核细胞型微生物非细胞型微生物1. 真核细胞型微生物的结构中有:细胞核,细胞质,细胞膜,细胞器。
如:真菌2.原核细胞型微生物结构中有:核质,细胞膜,细胞壁如:细菌、衣原体、支原体、立克次体、螺旋体、放线菌。
3.非细胞型微生物是由核酸(D N A/R N A)和蛋白质组成。
如:病毒。
三、微生物与人类的关系有益的方面:1、参与自然界中C、N、S等元素的循环。
2、农业方面:杀虫、造肥、固氮……3、工业方面:食品发酵、石油脱蜡……4、医药方面:制药、正常菌群……有害的方面:1、引起人类及动植物病害2、导致工业产品、农副产品和生活用品的腐烂和霉烂。
四、微生物学的分类微生物学是研究微生物的类型、分布、形态、结构、代谢、生长繁殖、遗传、进化,以及与人类、动植物等相互关系的科学。
微生物学具其研究的对象不同,有如下分支学科:•医学微生物学•兽医微生物学•农业微生物学•工业微生物学•药学微生物学五、医学微生物学发展史微生物的发展过程大致可分三个时期:1.实验微生物学时期------微生物的发现及病原微生物学的建立:代表人物、事件有:Leeuwenhoek----显微镜Pasteur----巴氏消毒法Koch----分离细菌,郭霍法则Iwanovsky----烟草花叶病毒Loeffler,Frosch----口蹄疫病毒Walter-Reed----黄热病毒Twort----噬菌体2.实验微生物学时期------抗感染免疫、化学疗法及抗生素的发现:代表人物、事件有:Jenner----牛痘预防天花Pasteur----霍乱、炭疽、狂犬疫苗Behring----白喉抗毒素меЧНИкоВИИ----吞噬细胞学说Ehrlich----体液抗体学说Wright----体液免疫、细胞免疫Ehrlich----砷凡纳明Fleming,Florey----青霉素3.现代微生物学时期(1)新病原微生物的发现朊病毒,军团菌,幽门螺杆菌,人类免疫缺陷病毒,埃博拉病毒,SARS病毒等……(2)病原微生物致病性的认识内源性感染,细菌耐药性,分子水平上的致病机制的研究……(3)微生物学诊断技术快速、准确、简易;ELISA,PCR……(4)微生物的防治措施新型疫苗的研制: 核酸疫苗,基因工程疫苗……本章重点习题1、解释名词:微生物微生物学2、微生物可分为几种类型?各型的结构有何特点?3、微生物的发展经历了那几个阶段?每段各举一例代表事件、代表人物。